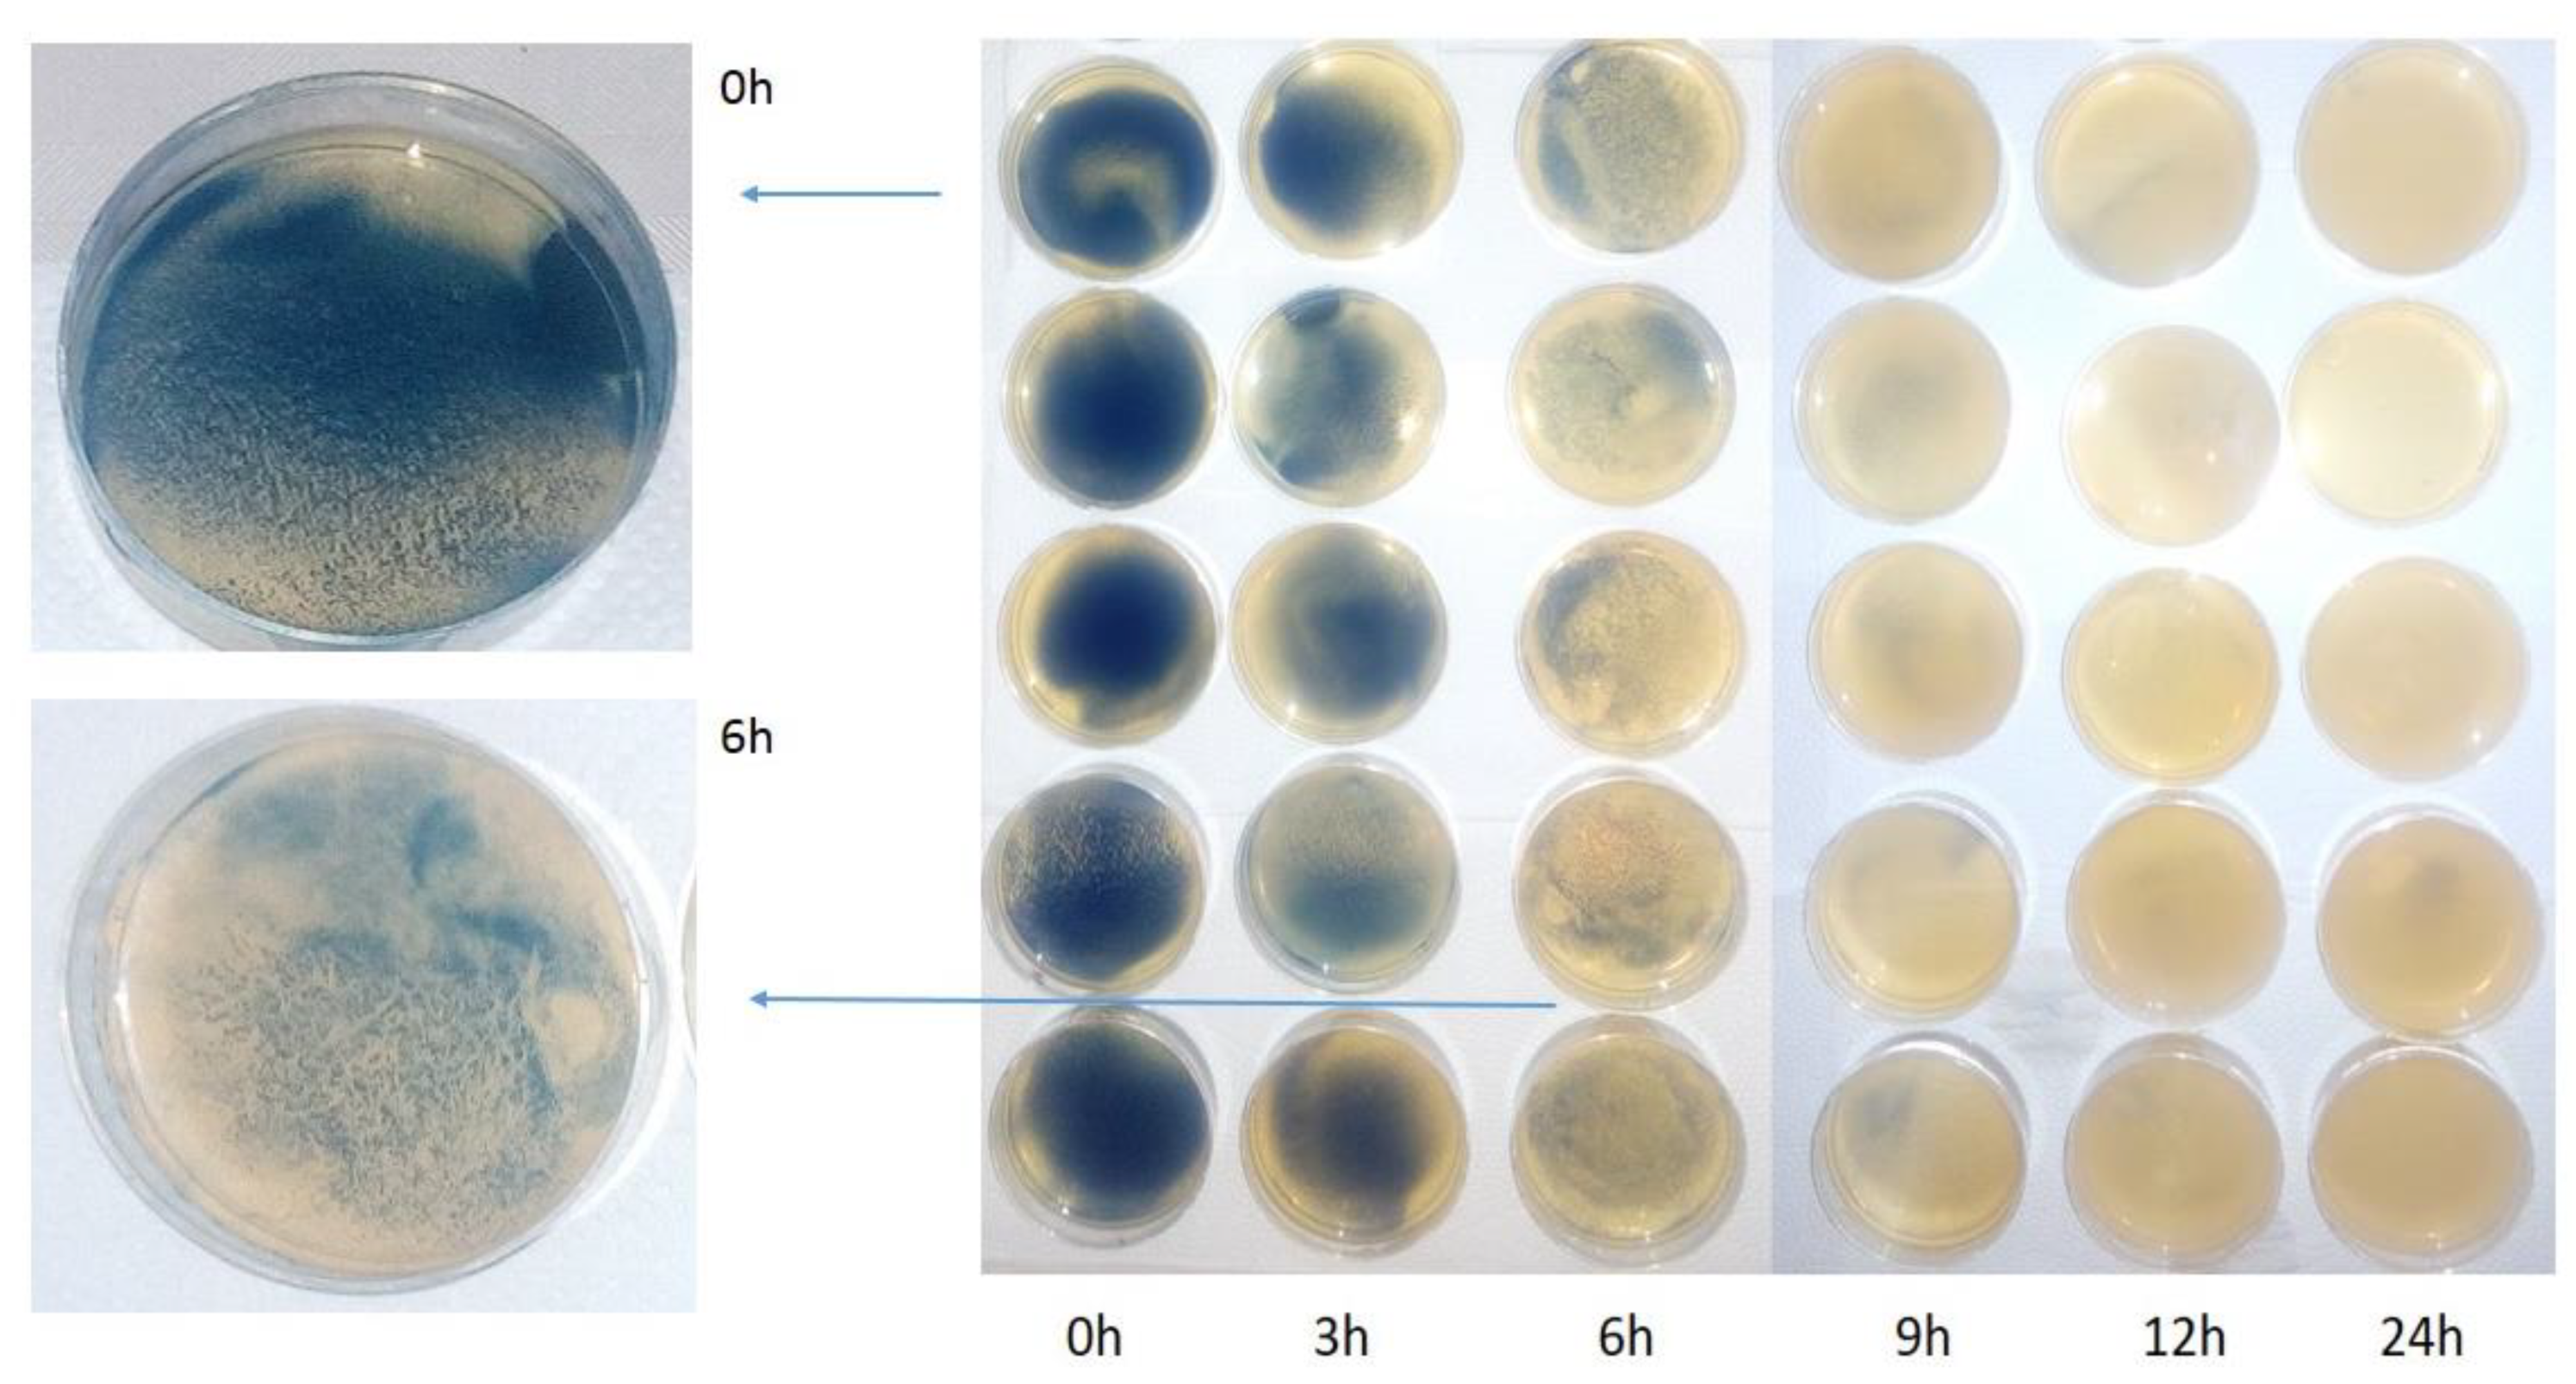
Materials 14 03086 g004 Materials 14 03086 g004
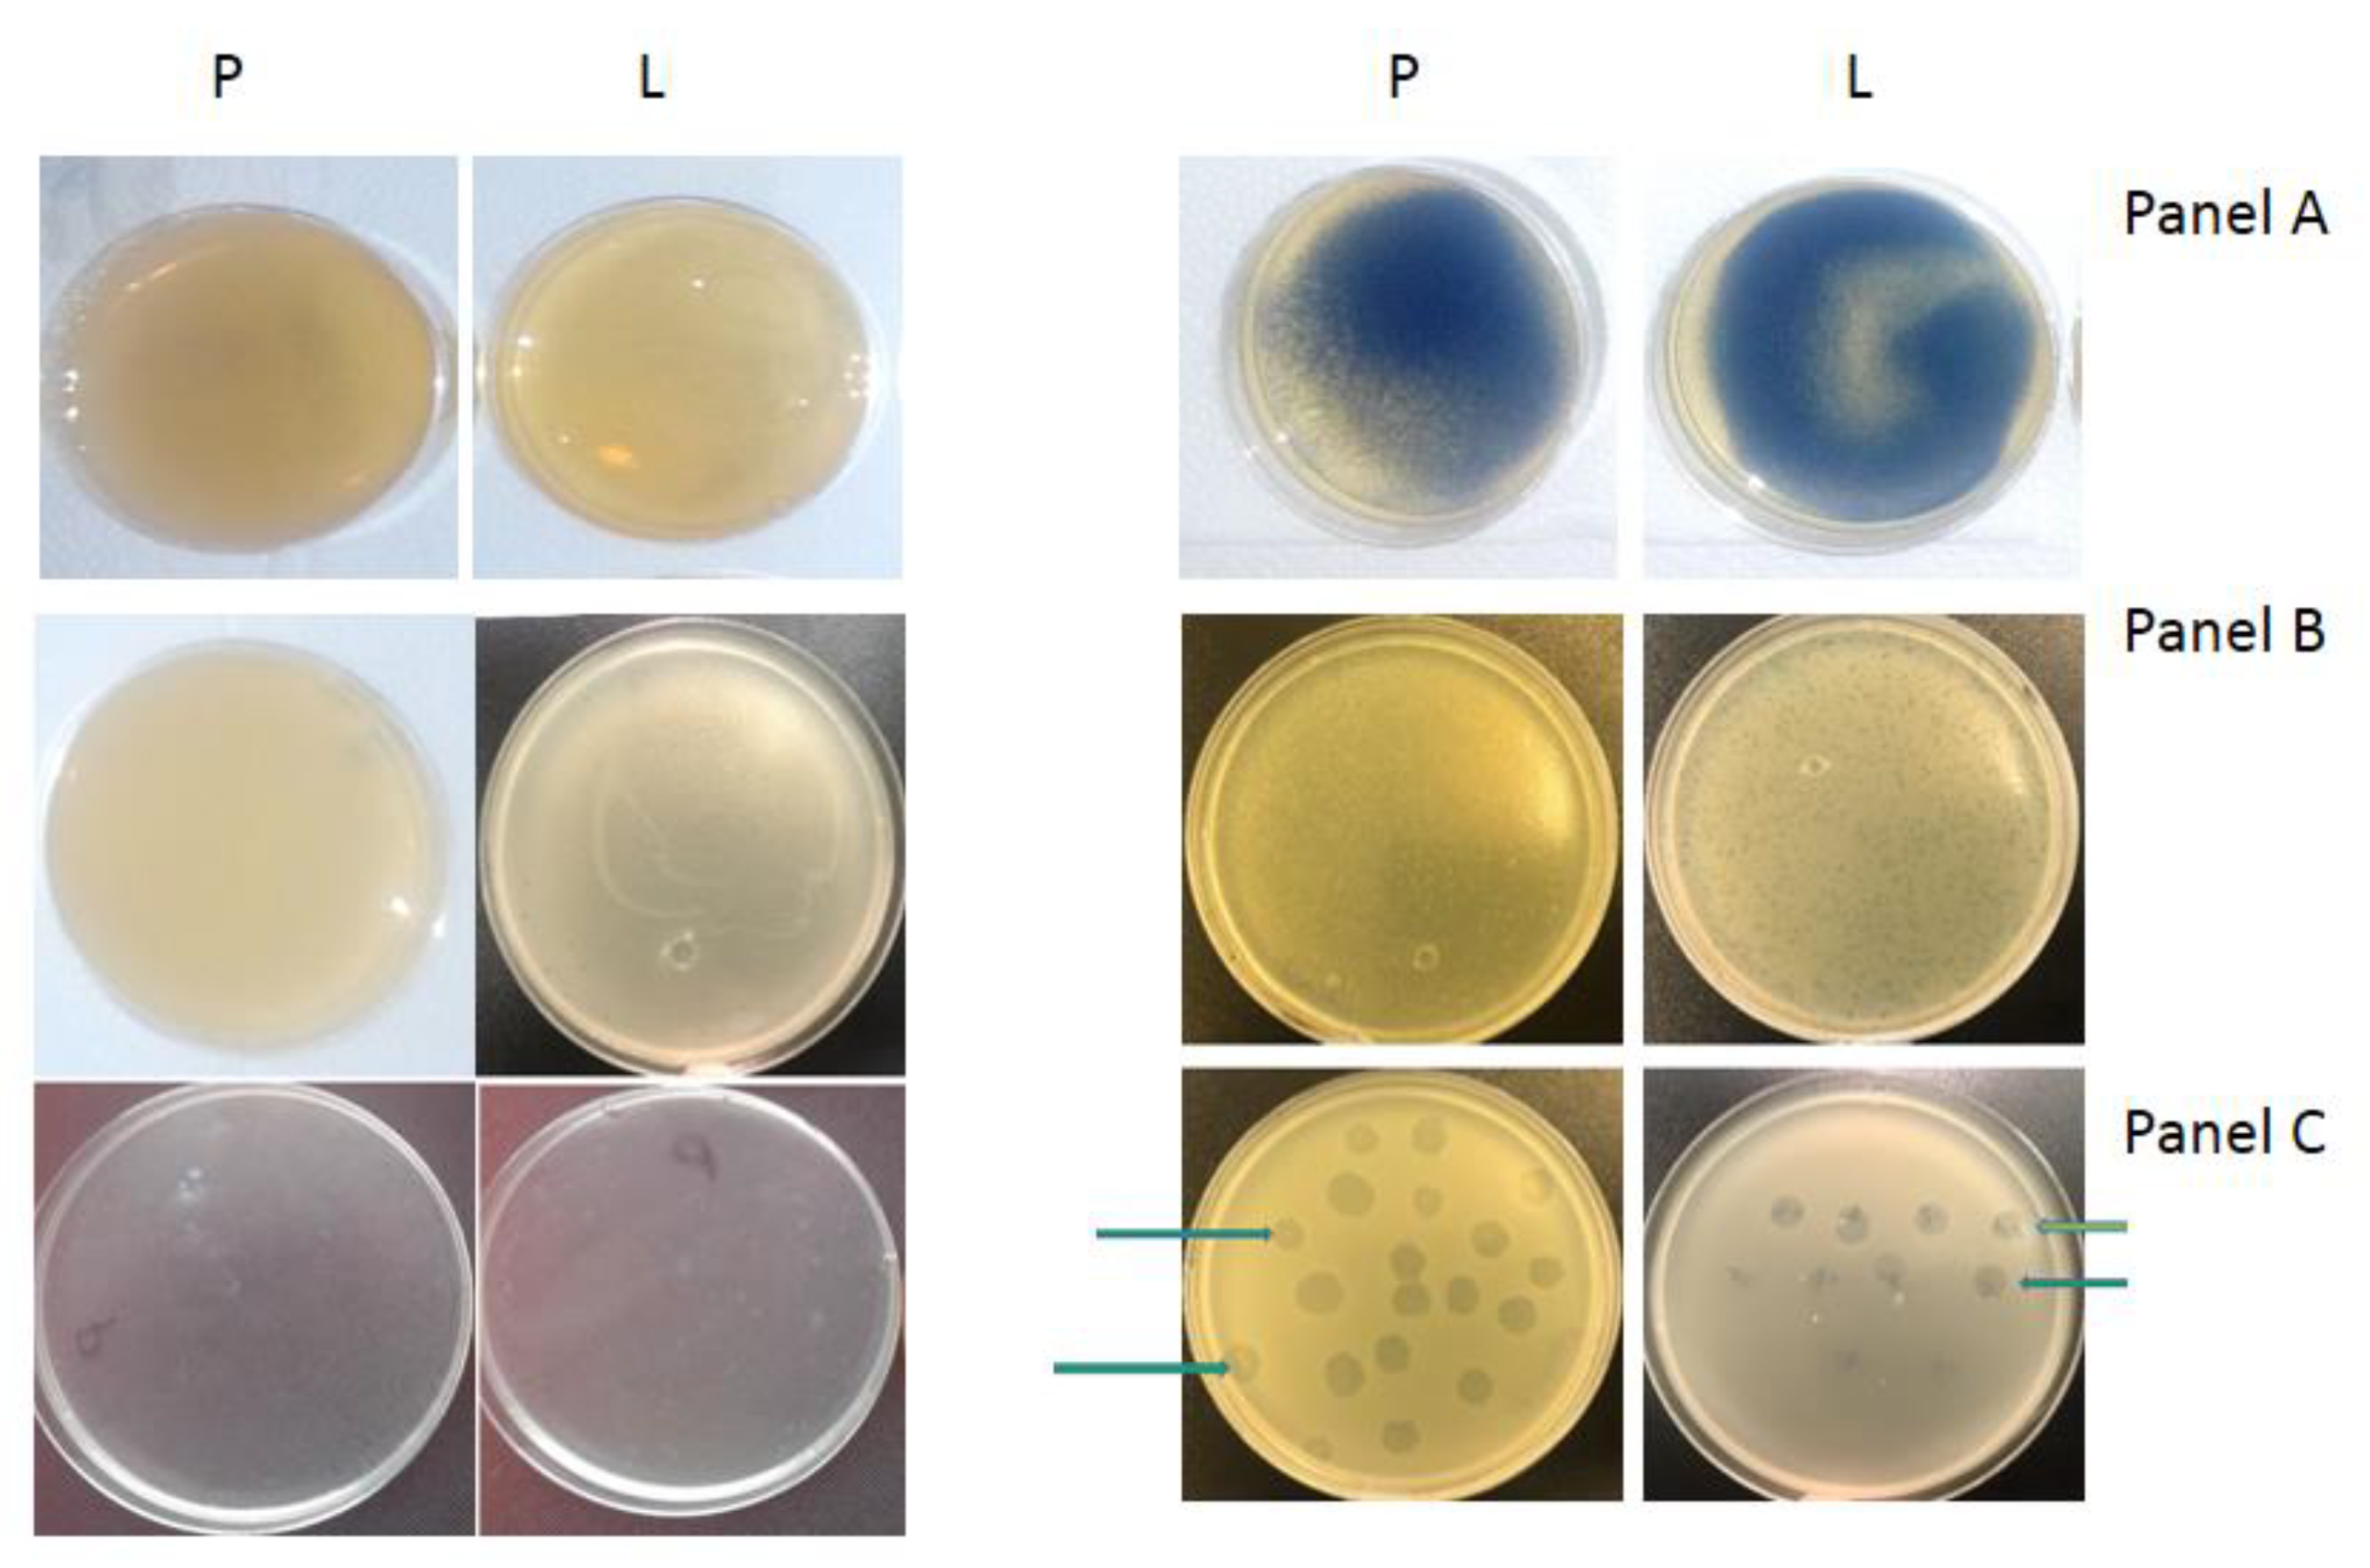
Materials 14 03086 g006 Materials 14 03086 g006

Protective Action of L. salivarius SGL03 and Lactoferrin against COVID-19 Infections in Human Nasopharynx
Abstract
1. Introduction
2. Materials and Methods
2.1. Checking If There Was SARS-CoV-2 Virus in Oral Microbiota and Nasopharynx after Treatment of SALISTAT SGL03 Collected from Healthy Volunteers and Infected Individuals
2.2. Analysis of SARS-CoV-2
3. Results
4. Discussion
5. Conclusions
Author Contributions
Funding
Institutional Review Board Statement
Informed Consent Statement
Data Availability Statement
Conflicts of Interest
Abbreviations
| MIC | Minimum inhibitory concentration |
| MBC | Minimum bactericidal concentration |
| SARS | Severe Acute Respiratory Syndrome |
| L. salivarius | LigiLactobacillus salivarius |
| S. pyogenes | Streptococcus pyogenes |
| S. sanguinis | Streptococcus sanguinis |
| S. mutans | Streptococcus mutans |
References
- Ammons, M.C.; Copie, V. Mini-review: Lactoferrin: A bioinspired, anti-biofilm therapeutic. Biofouling 2013, 29, 443–455. [Google Scholar] [CrossRef]
- Allaker, R.P.; Stephen, A.S. Use of Probiotics and Oral Health. Curr. Oral Health Rep. 2017, 4, 309–318. [Google Scholar] [CrossRef] [PubMed]
- Mancinelli, R.; Rosa, L.; Cutone, A.; Lepanto, M.S.; Franchitto, A.; Onori, P.; Gaudio, E.; Valenti, P. Viral Hepatitis and Iron Dysregulation: Molecular Pathways and the Role of Lactoferrin. Molecules 2020, 25, 1997. [Google Scholar] [CrossRef] [PubMed]
- Berlutti, F.; Pilloni, A.; Pietropaoli, M.; Polimeni, A.; Valenti, P. Lactoferrin and oral diseases: Current status and perspective in periodontitis. Ann. Stomatol. 2011, 2, 10–18. [Google Scholar]
- Chaves, B.D.; Brashears, M.M.; Nightingale, K.K. Applications and safety considerations of Lactobacillus salivarius as a probiotic in animal and human health. J. Appl. Microbiol. 2017, 123, 18–28. [Google Scholar] [CrossRef] [PubMed]
- Darveau, R.; Hajishengallis, G.; Curtis, M. Porphyromonas gingivalis as a Potential Community Activist for Disease. J. Dent. Res. 2012, 91, 816–820. [Google Scholar] [CrossRef] [PubMed]
- Gibbons, R. Role of Adhesion in Microbial Colonization of Host Tissues: A Contribution of Oral Microbiology. J. Dent. Res. 1996, 75, 866–870. [Google Scholar] [CrossRef]
- Food and Agriculture Organization and World Health Organization. Guidelines for the Evaluation of Probiotics in Food—Report of a Joint FAO/WHO Working Group on Drafting Guidelines for the Evaluation of Probiotics in Food; World Health Organization: Geneva, Switzerland, 2002.
- Guo, Y.; Nguyen, K.A.; Potempa, J. Dichotomy of gingipains action as virulence factors: From cleaving substrates with the precision of a surgeon’s knife to a meat chopper-like brutal degradation of proteins. Periodontology 2010, 54, 15–44. [Google Scholar] [CrossRef] [PubMed]
- Gui, M.; Dashper, S.G.; Slakeski, N.; Chen, Y.Y.; Reynolds, E.C. Spheres of influence: Porphyromonas gingivalis outer membrane vesicles. Mol. Oral Microbiol. 2016, 31, 365–378. [Google Scholar] [CrossRef]
- Grenier, D.; Roy, S.; Chandad, F.; Plamondon, P.; Yoshioka, M.; Nakayama, K.; Mayrand, D. Effect of Inactivation of the Arg- and/or Lys-Gingipain Gene on Selected Virulence and Physiological Properties of Porphyromonas gingivalis. Infect. Immun. 2003, 71, 4742–4748. [Google Scholar] [CrossRef]
- Ishida, N.; Ishihara, Y.; Ishida, K.; Tada, H.; Funaki-Kato, Y.; Hagiwara, M.; Ferdous, T.; Abdullah, M.; Mitani, A.; Michikawa, M.; et al. Periodontitis induced by bacterial infection exacerbates features of Alzheimer’s disease in transgenic mice. NPJ Aging Mech. Dis. 2017, 6, 3–15. [Google Scholar] [CrossRef]
- Jayaram, P.; Chatterjee, A.; Raghunathan, V. Probiotics in the treatment of periodontal disease: A systematic review. J. Indian Soc. Periodontol. 2016, 20, 488–495. [Google Scholar] [CrossRef] [PubMed]
- Jimenez, M.; Giovannucci, E.; Kaye, E.K.; Joshipura, K.J.; Dietrich, T. Predicted vitamin D status and incidence of tooth loss and periodontitis. Public Health Nutr. 2013, 17, 844–852. [Google Scholar] [CrossRef] [PubMed]
- Jenssen, H.; Hancock, R.E. Antimicrobial properties of lactoferrin. Biochimie 2009, 91, 19–29. [Google Scholar] [CrossRef] [PubMed]
- Jagiellonian Innovation Center. In Vitro Test Report: Antibacterial Action of the Salistat Diet Supplement Containing Lactobacillus salivarius SGL 03, Lactoferrin, GOS and Lemon and Rosemary Oils on Streptococcus pyogenes, Streptococcus sanguinis and Streptococcus mutans. Available online: https://en.uj.edu.pl/research/innovation (accessed on 26 September 2020).
- Slavkin, H.C. Biofilms, Microbial Ecology and Antoni van Leeuwenhoek. J. Am. Dent. Assoc. 1997, 128, 492–495. [Google Scholar] [CrossRef] [PubMed]
- Yeo, S.; Lee, S.; Park, H.; Shin, H.; Holzapfel, W.; Huh, C.S. Development of putative probiotics as feed additives: Validation in a porcine-specific gastrointestinal tract model. Appl. Microbiol. Biotechnol. 2016, 100, 10043–10054. [Google Scholar] [CrossRef] [PubMed]
- Kadowaki, T.; Baba, A.; Abe, N.; Takii, R.; Hashimoto, M.; Tsukuba, T.; Okazaki, S.; Suda, Y.; Asao, T.; Yamamoto, K. Suppression of pathogenicity of Porphyromonas gingivalis by newly developed gingipain inhibitors. Mol. Pharmacol. 2004, 66, 1599–1606. [Google Scholar] [CrossRef]
- Katz, J.; Chegini, N.; Shiverick, K.; Lamont, R. Localization of P. gingivalis in Preterm Delivery Placenta. J. Dent. Res. 2009, 88, 575–578. [Google Scholar] [CrossRef]
- Kaye, E.K.; Bs, A.V.; Baba, N.; Spiro, A.; Dietrich, T.; Garcia, R.I. Tooth Loss and Periodontal Disease Predict Poor Cognitive Function in Older Men. J. Am. Geriatr. Soc. 2010, 58, 713–718. [Google Scholar] [CrossRef] [PubMed]
- Mayanagi, G.; Kimura, M.; Nakaya, S.; Hirata, H.; Sakamoto, M.; Benno, Y.; Shimauchi, H. Probiotic effects of orally administered Lactobacillus salivarius WB21-containing tablets on periodontopathic bacteria: A double-blinded, placebo-controlled, randomized clinical trial. J. Clin. Peridontol. 2009, 36, 506–513. [Google Scholar] [CrossRef] [PubMed]
- Kowalczyk, P.; Borkowski, A.; Czerwonka, G.; Cłapa, T.; Cieśla, J.; Misiewicz, A.; Borowiec, M.; Szala, M. The microbial toxicity of quaternary ammonium ionic liquids is dependent on the type of lipopolysaccharide. J. Mol. Liq. 2018, 266, 540–547. [Google Scholar] [CrossRef]
- Shimauchi, H.; Mayanagi, G.; Nakaya, S.; Minamibuchi, M.; Ito, Y.; Yamaki, K.; Hirata, H. Improvement of periodontal condition by probiotics with Lactobacillus salivarius WB21: A randomized, double-blind, placebo-controlled study. J. Clin. Periodontol. 2008, 35, 897–905. [Google Scholar] [CrossRef] [PubMed]
- Neville, B.A.; O’Toole, P.W. Probiotic properties of Lactobacillus salivarius and closely related Lactobacillus species. Future Microbiol. 2010, 5, 759–774. [Google Scholar] [CrossRef] [PubMed]
- Paik, S.; Senty, L.; Das, S.; Noe, J.C.; Munro, C.L.; Kitten, T. Identification of Virulence Determinants for Endocarditis in Streptococcus sanguinis by Signature-Tagged Mutagenesis. Infect. Immun. 2005, 73, 6064–6074. [Google Scholar] [CrossRef]
- Pidutti, P.; Federici, F.; Brandi, J.; Manna, L.; Rizzi, E.; Marini, U.; Cecconi, D. Purification and characterization of ribosomal proteins L27 and L30 having antimicrobial activity produced by the Lactobacillus salivarius SGL 03. J. Appl. Microbiol. 2018, 124, 398–407. [Google Scholar] [CrossRef] [PubMed]
- Sheets, S.M.; Potempa, J.; Travis, J.; Casiano, C.A.; Fletcher, H.M. Gingipains from Porphyromonas gingivalis W83 Induce Cell Adhesion Molecule Cleavage and Apoptosis in Endothelial Cells. Infect. Immun. 2005, 73, 1543–1552. [Google Scholar] [CrossRef] [PubMed]
- Smiley, C.J.; Tracy, S.L.; Abt, E.; Michalowicz, B.S.; John, M.T.; Gunsolley, J.; Cobb, C.M.; Rossmann, J.; Harrel, S.K.; Forrest, J.L.; et al. Evidence-based clinical practice guideline on the nonsurgical treatment of chronic periodontitis by means of scaling and root planing with or without adjuncts. J. Am. Dent. Assoc. 2015, 146, 525–535. [Google Scholar] [CrossRef]
- Windsor, L.J.A.S. Effects of Porphyromonas gingivalis on human gingival fibroblasts from healthy and inflamed tissues. J. Peridont. Res. 2008, 43, 465–470. [Google Scholar]
- Colombo, A.V.; Silva, C.M.; Haffajee, A.; Colombo, A.P.V. Identification of oral bacteria associated with crevicular epithelial cells from chronic periodontitis lesions. J. Med. Microbiol. 2006, 55, 609–615. [Google Scholar] [CrossRef] [PubMed]
- Cutler, C.W.; Kalmar, J.R.; Genco, C.A. Pathogenic strategies of the oral anaerobe Porhyromonas gingivalis. Trends Microbiol. 1995, 3, 45–51. [Google Scholar] [CrossRef]
- Duriez, C.; Moyret-Lalle, C.; Falette, N.; El-Ghissassi, F.; Puisieux, A. BTG2, its family and its tutor. Bull. Cancer 2004, 91, E242–E253. [Google Scholar]
- Haffajee, A.D.; Socransky, S.S.; Patel, M.R.; Song, X. Microbial complexes in supragingival plaque. Oral Microbiol. Immunol. 2008, 23, 196–205. [Google Scholar] [CrossRef] [PubMed]
- Haffajee, A.D.; Teles, R.P.; Socransky, S.S. The effect of periodontal therapy on the composition of the subgingival micro-biota. Periodontology 2000, 42, 219–258. [Google Scholar] [CrossRef] [PubMed]
- Holt, S.C.; Kesavalu, L.; Walker, S.; Genco, C.A. Virulence factors of Porphyromonas gingivalis. Periodontology 1999, 20, 168–238. [Google Scholar] [CrossRef] [PubMed]
- Jain, S.; Darveau, R.P. Contribution of Porphyromonas gingivalis lipopolysaccharide to periodontitis. Periodontology 2010, 54, 53–70. [Google Scholar] [CrossRef]
- Kim, Y.C.; Ko, Y.; Hong, S.D.; Kim, K.Y.; Lee, Y.H.; Chae, C.; Choi, Y. Presence of Porphyromonas gingivalis and plasma cell dominance in gingival tissues with periodontitis. Oral Dis. 2010, 16, 375–381. [Google Scholar] [CrossRef] [PubMed]
- Nedzi-Góra, M.; Kowalski, J.; Krajewski, J.; Górska, R. Microbiological analysis of deep periodontal pockets in people with chronic periodontitis by PCR. Stomatol. J. 2007, 11, 717–725. [Google Scholar]
- Sbordone, L.; Di Genio, M.; Bortolaia, C. Bacterial virulence in the etiology of periodontal diseases. Minerva Stomatol. 2000, 49, 485–500. [Google Scholar] [PubMed]
- Scheres, N.; Crielaard, W. Gingival fibroblast responsiveness is differentially affected by Porphyromonas gingivalis: Implications for the pathogenesis of periodontitis. Mol. Oral Microbiol. 2012, 12, 1–15. [Google Scholar]
- Sela, M.N. Role of Treponema denticola in Periodontal Diseases. Crit. Rev. Oral Biol. Med. 2001, 12, 399–413. [Google Scholar] [CrossRef]
- Servin, A.L. Antagonistic activities of lactobacilli and bifidobacteria against microbial pathogens. FEMS Microbiol. Rev. 2004, 28, 405–440. [Google Scholar] [CrossRef] [PubMed]
- Socransky, S.S.; Haffajee, A.D.; Cugini, M.A.; Smith, C.; Kent, R.L. Microbial complexes in sub-gingival plaque. J. Clin. Periodontol. 1998, 25, 134–144. [Google Scholar] [CrossRef] [PubMed]
- Socransky, S.S.; Hffajee, A.D. Periodontal microbial ecology. Periodontology 2005, 38, 135–187. [Google Scholar] [CrossRef]
- Taylor, J.J. Cytokine regulation of immune responses to Porphyromonas gingivalis. Periodontology 2010, 54, 160–194. [Google Scholar] [CrossRef] [PubMed]
- Stamatova, I.; Meurman, J.H. Probiotics and periodontal disease. Periodontology 2009, 51, 141–151. [Google Scholar] [CrossRef] [PubMed]
- Tanner, A.C.R.; Izard, J. Tannerella forsythia, a periodontal pathogen entering the genomic era. Periodontology 2006, 42, 88–113. [Google Scholar] [CrossRef] [PubMed]
- Teanpaisan, R.; Piwat, S.; Dahlèn, G. Inhibitory effect of oral Lactobacillus against oral pathogens. Lett. Appl. Microbiol. 2011, 53, 452–459. [Google Scholar] [CrossRef]
- Testa, M.M.; de Valladares, R.; de Cardenas, I.L. Antagonistic interactions among Fusobacterium nucleatum and Prevotella intermedia with oral lactobacilli. Res. Microbiol. 2003, 154, 669–675. [Google Scholar] [CrossRef] [PubMed]
- Kowalczyk, P.; Madej, A.; Paprocki, D.; Szymczak, M.; Ostaszewski, R. Coumarin Derivatives as New Toxic Compounds to Selected K12, R1–R4 E. coli Strains. Materials 2020, 13, 2499. [Google Scholar] [CrossRef] [PubMed]
- Ilievski, V.; Zuchowska, P.K.; Green, S.J.; Toth, P.; Ragozzino, M.E.; Le, K.; Aljewari, H.W.; O’Brien-Simpson, N.M.; Reynolds, E.C.; Watanabe, K. Chronic oral application of a periodontal pathogen results in brain inflammation, neurodegeneration and amyloid beta production in wild type mice. PLoS ONE 2018, 13, e0204941. [Google Scholar] [CrossRef] [PubMed]
- Singhrao, S.K.; Olsen, I. Assessing the role of Porphyromonas gingivalis in periodontitis to determine a causative relationship with Alzheimer’s disease. J. Oral Microbiol. 2019, 11, 1563405. [Google Scholar] [CrossRef] [PubMed]
- Educational Committee of the International Society of Pediatric Dentistry (USA). Insights into the Mouth. Available online: www.czytelniamedyczna.pl/1905,wglad-do-jamyustnej.html (accessed on 26 September 2020).
- Pietrocola, G.; Ceci, M.; Preda, F.; Poggio, C.; Colombo, M. Evaluation of the antibacterial activity of a new ozonized olive oil against oral and periodontal pathogens. J. Clin. Exp. Dent. 2018, 10, e1103–e1108. [Google Scholar] [CrossRef] [PubMed]
- Nishihara, T.; Suzuki, N.; Yoneda, M.; Hirofuji, T. Effects of Lactobacillus salivarius-containing tablets on caries risk factors: A randomized open-label clinical trial. BMC Oral Health 2014, 14, 110. [Google Scholar] [CrossRef]
- Peret, A.; Kucia, M. Evaluation of the effects on oral health of using Salistat SGL03—A pilot study. Asyst. Hig. Stomatol. 2019, 56, 176–183. [Google Scholar]
- Fan, X.; Alekseyenko, A.; Wu, J.; Peters, B.A.; Jacobs, E.J.; Gapstur, S.M.; Purdue, M.P.; Abnet, C.C.; Stolzenberg-Solomon, R.; Miller, G.; et al. Human oral microbiome and prospective risk for pancreatic cancer: A population-based nested case-control study. Gut 2018, 67, 120–127. [Google Scholar] [CrossRef] [PubMed]
- Vogel, H.J. Lactoferrin, a bird’s eye view. Biochem. Cell Biol. 2012, 90, 233–244. [Google Scholar] [CrossRef] [PubMed]
- Baker, H.M.; Baker, E.N. Lactoferrin and iron: Structural and dynamic aspects of binding and release. Biometals 2004, 17, 209–216. [Google Scholar] [CrossRef]
- Artym, J. Lactoferrin—The guardian of iron absorption processes. Adv. Cell Biol. 2015, 45, 283–308. [Google Scholar]
- Moreno-Expósito, L.; Illescas-Montes, R.; Melguizo-Rodríguez, L.; Ruiz, C.; Ramos-Torrecillas, J.; de Luna-Bertos, E. Multifunctional capacity and therapeutic potential of lactoferrin. Life Sci. 2018, 195, 61–64. [Google Scholar] [CrossRef] [PubMed]
- Artym, J. Participation of lactoferrin in iron metabolism in the body. Hello II. Anti-microbial and anti-inflammatory effect through iron sequestration. Postepy Hig. Med. Dosw. 2010, 64, 604–616. [Google Scholar]
- Karav, S.; German, J.B.; Rouquié, C.; Le Parc, A.; Barile, D. Studying Lactoferrin N-Glycosylation. Int J. Mol. Sci. 2017, 18, 870. [Google Scholar] [CrossRef] [PubMed]
- Małaczewska, J.; Rotkiewicz, Z.; Siwicki, A.K. Lactoferrin: Mechanisms of antiviral action. Wet Med. 2006, 26, 1104–1107. [Google Scholar]
- García-Montoya, I.A.; Siqueiros Cendón, T.; Arévalo-Gallegos, S.; Rascón-Cruz, Q. Lactoferrin a multiple bioactive protein: An overview. Biochim. Biophys. Acta Gen. Subj. 2012, 1820, 226–236. [Google Scholar] [CrossRef]
- Adlerova, L.; Bartoskova, A.; Faldyna, M. Lactoferrin: A review. Vet. Med. 2008, 53, 457–468. [Google Scholar] [CrossRef]
- González-Chávez, S.A.; Arévalo-Gallegos, S.; Rascón-Cruz, Q. Lactoferrin: Structure, function and applications. Int. J. Antimicrob. Agents 2009, 33, 301.e1–301.e8. [Google Scholar] [CrossRef] [PubMed]
- Lauterbach, R.; Kamińska, E.; Michalski, P.; Lauterbach, J.P. Lactoferrin—A glycoprotein with great therapeutic potential. Dev. Period. Med. 2016, 20, 118–125. [Google Scholar] [PubMed]
- Lingappan, K.; Arunachalam, A.; Pammi, M. Lactoferrin and the newborn: Current perspectives. Expert Rev. Antiinfective Ther. 2013, 11, 695–707. [Google Scholar] [CrossRef]
- Siqueiros-Cendón, T.; Arévalo-Gallegos, S.; Iglesias-Figueroa, B.F.; García-Montoya, I.A.; Salazar-Martínez, J.; Rascón-Cruz, Q. Immunomodulatory effects of lactoferrin. Acta Pharmacol Sin. 2014, 35, 557–566. [Google Scholar] [CrossRef] [PubMed]
- Paesano, R.; Pietropaoli, M.; Berlutti, F.; Valenti, P. Bovine lactoferrin in preventing preterm delivery associated with sterile inflammation. Biochem. Cell Biol. 2012, 90, 468–475. [Google Scholar] [CrossRef]
- Zander, Z.; Zander, L.; Mickiewicz, D. Lactoferrin-multipotent milk protein. Innov. Dairy Farming 2014, 2, 18–21. [Google Scholar]
- Kucia, M.; Wietrak, E.; Szymczak, M.; Kowalczyk, P. Effect of Ligilactobacillus salivarius and Other Natural Components against Anaerobic Periodontal Bacteria. Molecules 2020, 25, 4519. [Google Scholar] [CrossRef] [PubMed]
- Sambrook, J.; Fritsch, E.F.; Maniatis, T. Molecular Cloning: A Laboratory Manual; Cold Spring Harbor Laboratory Press: Long Island, NY, USA, 1989. [Google Scholar]
- Messing, J. New M13 vectors for cloning. Methods Enzymol. 1983, 101, 20–78. [Google Scholar] [PubMed]
- Da Silva, J.K.R.; Figueiredo, P.L.B.; Byler, K.G.; Setzer, W.N. Essential Oils as Antiviral Agents, Potential of Essential Oils to Treat SARS-CoV-2 Infection: An In-Silico Investigation. Int. J. Mol. Sci. 2020, 21, 3426. [Google Scholar] [CrossRef]
- Avorn, J.L.; Barrett, J.F.; Davey, P.G.; McEwen, S.A.; O’Brien, T.F.; Levy, S.B. Antibiotic Resistance: Synthesis of Recommendations by Expert Policy Groups; World Health Organization: Boston, MA, USA, 2000.
- Hojyo, S.; Uchida, M.; Tanaka, K.; Hasebe, R.; Tanaka, Y.; Murakami, M.; Hirano, T. How COVID-19 induces cytokine storm with high mortality. Inflamm. Regen. 2020, 40, 1–7. [Google Scholar] [CrossRef] [PubMed]
- World Health Organization. Infection Prevention and Control of Epidemic-and Pandemic-Prone Acute Respiratory Infections in Health Care. Available online: https://apps.who.int/iris/bitstream/handle/10665/112656/9789241507134_eng.pdf;jsessionid=41AA684FB64571CE8D8A453C4F2B2096?sequence=1 (accessed on 31 January 2021).
- Van Doremalen, N.; Bushmaker, T.; Morris, D.H.; Holbrook, M.G.; Gamble, A.; Williamson, B.N.; Tamin, A.; Harcourt, J.L.; Thornburg., N.J.; Gerber, S.I.; et al. Aerosol and surface stability of SARS-CoV-2 as compared with SARS-CoV-1. N. Engl. J. Med. 2020, 382, 1564–1567. [Google Scholar] [CrossRef] [PubMed]
- Fears, A.C.; Klimstra, W.B.; Duprex, P.; Weaver, S.C.; Plante, J.A.; Aguilar, P.V.; Fernández, D.; Nalca, A.; Totura, A.; Dyer, D.; et al. Persistence of Severe Acute Respiratory Syndrome Coronavirus 2 in Aerosol Suspensions. Emerg. Infect. Dis. 2020, 26. [Google Scholar] [CrossRef] [PubMed]
- Jones, D.L.; Baluja, M.Q.; Graham, D.W.; Corbishley, A.; McDonald, J.E.; Malham, S.K.; Hillary, L.S.; Connor, T.R.; Gaze, W.H.; Moura, I.B.; et al. Shedding of SARS-CoV-2 in feces and urine and its potential role in person-to-person transmission and the environment-based spread of COVID-19. Sci. Total Environ. 2020, 749, 141364. [Google Scholar] [CrossRef]
- Guo, Z.-D.; Wang, Z.-Y.; Zhang, S.-F.; Li, X.; Li, L.; Li, C.; Cui, Y.; Fu, R.-B.; Dong, Y.-Z.; Chi, X.-Y.; et al. Aerosol and Surface Distribution of Severe Acute Respiratory Syndrome Coronavirus 2 in Hospital Wards, Wuhan, China, 2020. Emerg. Infect. Dis. 2020, 26, 1583–1591. [Google Scholar] [CrossRef] [PubMed]
- Liu, Y.; Ning, Z.; Chen, Y.; Guo, M.; Liu, Y.; Gali, N.K.; Sun, L.; Duan, Y.; Cai, J.; Westerdahl, D.; et al. Aerodynamic analysis of SARS-CoV-2 in two Wuhan hospitals. Nature 2020, 582, 557–560. [Google Scholar] [CrossRef] [PubMed]
- Cheng, V.C.-C.; Wong, S.-C.; Chan, V.W.-M.; So, S.Y.-C.; Chen, J.H.-K.; Yip, C.C.-Y.; Chan, K.H.; Chu, H.; Chung, T.W.H.; Sridhar, S.; et al. Air and environmental sampling for SARS-CoV-2 around hospitalized infected individuals with coronavirus disease 2019 (COVID-19). Infect. Control. Hosp. Epidemiol. 2020, 1–32. [Google Scholar] [CrossRef]
- Ong, S.W.X.; Tan, Y.K.; Chia, P.Y.; Lee, T.H.; Ng, O.T.; Wong, M.S.Y.; Marimuthu, K. Air, Surface Environmental, and Personal Protective Equipment Contamination by Severe Acute Respiratory Syndrome Coronavirus 2 (SARS-CoV-2) From a Symptomatic Patient. JAMA 2020, 323, 1610–1612. [Google Scholar] [CrossRef] [PubMed]
- Wu, S.; Wang, Y.; Jin, X.; Tian, J.; Liu, J.; Mao, Y. Environmental contamination by SARS-CoV-2 in a designated hospital for coronavirus disease 2019. Am. J. Infect. Control. 2020, 48. [Google Scholar] [CrossRef]
- Cheng, V.C.C.; Wong, S.C.; Chen, J.H.K.; Yip, C.C.Y.; Chuang, V.W.M.; Tsang, O.T.Y.; Sridhar, S.; Chan, J.F.W.; Ho, P.-L.; Yuen, K.-Y. Escalating infection control response to the rapidly evolving epidemiology of the coronavirus disease 2019 (COVID-19) due to SARS-CoV-2 in Hong Kong. Infect. Control. Hosp. Epidemiol. 2020, 41, 493–498. [Google Scholar] [CrossRef] [PubMed]
- Bullard, J.; Dust, K.; Funk, D.; Strong, J.E.; Alexander, D.; Garnett, L.; Boodman, C.; Bello, A.; Hedley, A.; Schiffman, Z.; et al. Predicting infectious SARS-CoV-2 from diagnostic samples. Clin. Infect. Dis. 2020, 71. [Google Scholar] [CrossRef]
- Mazucanti, C.H.; Egan, J.M. SARS-CoV-2 disease severity and diabetes: Why the connection and what is to be done? Immun. Ageing 2020, 17, 1–11. [Google Scholar] [CrossRef] [PubMed]
- Khan, A.I.; Liu, J.; Dutta, P. Bayesian inference for parameter estimation in lactoferrin-mediated iron transport across blood-brain barrier. Biochim. Biophys. Acta Gen. Subj. 2020, 1864, 129459. [Google Scholar] [CrossRef]
- Kell, D.B.; Heyden, E.L.; Pretorius, E. The Biology of Lactoferrin, an Iron-Binding Protein That Can Help Defend against Viruses and Bacteria. Front. Immunol. 2020, 11, 1221. [Google Scholar] [CrossRef] [PubMed]
- Yang, J.; Petitjean, S.J.L.; Koehler, M.; Zhang, Q.; Dumitru, A.C.; Chen, W.; Derclaye, S.; Vincent, S.P.; Soumillion, P.; Alsteens, D. Molecular interaction and inhibition of SARS-CoV-2 binding to the ACE2 receptor. Nat. Commun. 2020, 11. [Google Scholar] [CrossRef]
- Statkute, E.; Rubina, A.; O’Donnell, V.B.; David, W. Thomas2† Richard, J.; Stanton, T.R.J. The Virucidal Efficacy of Oral Rinse Components against SARS-CoV-2 In Vitro. bioRxiv 2020. [Google Scholar] [CrossRef]
- Carrouel, F.; Gonçalves, L.; Conte, M.; Campus, G.; Fisher, J.; Fraticelli, L.; Gadea-Deschamps, E.; Ottolenghi, L.; Bourgeois, D. Antiviral Activity of Reagents in Mouth Rinses against SARS-CoV-2. J. Dent. Res. 2021, 100, 124–132. [Google Scholar] [CrossRef] [PubMed]
- Choi, H.-J. Chemical Constituents of Essential Oils Possessing Anti-Influenza A/WS/33 Virus Activity. Osong Public Health Res. Perspect. 2018, 9, 348–353. [Google Scholar] [CrossRef]
- Kowalczyk, P.; Cieśla, J.; Komisarski, M.; Kuśmierek, J.T.; Tudek, B. Long-chain adducts of trans-4-hydroxy-2-nonenal to DNA bases cause recombination, base substitutions and frameshift mutations in M13 phage. Mutat. Res. Mol. Mech. Mutagen. 2004, 550, 33–48. [Google Scholar] [CrossRef]
- Wakabayashi, H.; Yamauchi, K.; Abe, F. Quality control of commercial bovine lactoferrin. BioMetals 2018, 31, 313–319. [Google Scholar] [CrossRef]
- Gutone, A.; Rosa, L.; Ianiro, G.; Lepanto, M.S.; di Patti, M.C.B.; Valenti, P.; Musci, G. Lactoferrin’s Anti-Cancer Properties: Safety, Selectivity, and Wide Range of Action. Biomolecules 2020, 10, 456. [Google Scholar] [CrossRef]
- Serrano, G.; Kochergina, I.; Albors, A.; Diaz, E.; Oroval, M.; Hueso, G.; Serrano, J.M. Liposomal Lactoferrin as Potential Preventative and Cure for COVID-19. Int. J. Res. Health Sci. 2020, 8, 08–15. [Google Scholar] [CrossRef]
- Ishikado, A.; Imanaka, H.; Takeuchi, T.; Harada, E.; Makino, T. Liposomalization of Lactoferrin Enhanced It’s Anti-inflammatory Effects via Oral Administration. Biol. Pharm. Bull. 2005, 28, 1717–1721. [Google Scholar] [CrossRef]
- Bruni, N.; Capucchio, M.T.; Biasibetti, E.; Pessione, E.; Cirrincione, S.; Giraudo, L.; Corona, A.; Dosio, F. Antimicrobial Activity of Lactoferrin-Related Peptides and Applications in Human and Veterinary Medicine. Molecules 2016, 21, 752. [Google Scholar] [CrossRef] [PubMed]
- Zhu, N.; Zhang, D.; Wang, W.; Li, X.; Yang, B.; Song, J.; Zhao, X.; Huang, B.; Shi, W.; Lu, R.; et al. A Novel Coronavirus from Patients with Pneumonia in China, 2019. N. Engl. J. Med. 2020, 382, 727–733. [Google Scholar] [CrossRef]
- Calina, D.; Docea, A.O.; Petrakis, D.; Egorov, A.M.; Ishmukhametov, A.A.; Gabibov, A.G.; Shtilman, M.I.; Kostoff, R.; Carvalho, F.; Vinceti, M.; et al. Towards effective COVID-19 vaccines: Updates, perspectives and challenges (Review). Int. J. Mol. Med. 2020, 46, 3–16. [Google Scholar] [CrossRef]
- Legrand, D.; Elass, E.; Carpentier, M.; Mazurier, J. Interactions of lactoferrin with cells involved in immune function. Biochem. Cell Biol. 2006, 84, 282–290. [Google Scholar] [CrossRef]
- Levay, P.F.; Viljoen, M. Lactoferrin: A general review. Haematologica 1995, 80, 252–267. [Google Scholar] [PubMed]
- Kaito, M.; Iwasa, M.; Fujita, N.; Kobayashi, Y.; Kojima, Y.; Ikoma, J.; Imoto, I.; Adachi, Y.; Hamano, H.; Yamauchi, K. Effect of lactoferrin in patients with chronic hepatitis C: Combination therapy with interferon and ribavirin. J. Gastroenterol. Hepatol. 2007, 22, 1894–1897. [Google Scholar] [CrossRef] [PubMed]
- Hong, H.; Wang, Y.; Chung, H.-T.; Chen, C.-J. Clinical characteristics of novel coronavirus disease 2019 (COVID-19) in newborns, infants and children. Pediatr. Neonatol. 2020, 61, 131–132. [Google Scholar] [CrossRef] [PubMed]
- Wei, M.; Yuan, J.; Liu, Y.; Fu, T.; Yu, X.; Zhang, Z.-J. Novel Coronavirus Infection in Hospitalized Infants Under 1 Year of Age in China. JAMA 2020, 323, 1313. [Google Scholar] [CrossRef]
- Chang, R.; Ng, T.B.; Sun, W.-Z. Lactoferrin as potential preventative and adjunct treatment for COVID-19. Int. J. Antimicrob. Agents 2020, 56, 106118. [Google Scholar] [CrossRef]
- Tian, M.; Han, J.; Ye, A.; Liu, W.; Xu, X.; Yao, Y.; Li, K.; Kong, Y.; Wei, F.; Zhou, W.J. Structural characterization and biological fate of lactoferrin-loaded liposomes during simulated infant digestion. Sci. Food Agric. 2019, 99, 2677–2684. [Google Scholar] [CrossRef]
- Safaeian, L.; Sajjadi, S.; Javanmard, S.; Montazeri, H.; Samani, F. Protective effect of Melissa officinalis extract against H2O2-induced oxidative stress in human vascular endothelial cells. Res. Pharm. Sci. 2016, 11, 383–389. [Google Scholar] [CrossRef]
- Li, S.; Zhou, H.; Huang, G.; Liu, N. Inhibition of HBV infection by bovine lactoferrin and iron-, zinc-saturated lactoferrin. Med. Microbiol. Immunol. 2008, 198, 19–25. [Google Scholar] [CrossRef]
- Mrityunjaya, M.; Pavithra, V.; Neelam, R.; Janhavi, P.; Halami, P.M.; Ravindra, P.V. Immune-Boosting, Antioxidant and Anti-inflammatory Food Supplements Targeting Pathogenesis of COVID-19. Front. Immunol. 2020, 11, 570122. [Google Scholar] [CrossRef]
- Russo, R.; Karadja, E.; De Seta, F. Evidence-based mixture containing Lactobacillus strains and lactoferrin to prevent recurrent bacterial vaginosis: A double blind, placebo controlled, randomised clinical trial. Benef. Microbes 2019, 10, 19–26. [Google Scholar] [CrossRef]
- Cegolon, L.; Mirandola, M.; Salaris, C.; Salvati, M.; Mastrangelo, G.; Salata, C. Hypothiocyanite and Hypothiocyanite/Lactoferrin Mixture Exhibit Virucidal Activity In Vitro against SARS-CoV-2. Pathogens 2021, 10, 233. [Google Scholar] [CrossRef] [PubMed]
- Habib, H.M.; Ibrahim, S.; Zaim, A.; Ibrahim, W.H. The role of iron in the pathogenesis of COVID-19 and possible treatment with lactoferrin and other iron chelators. Biomed. Pharmacother. 2021, 136, 111228. [Google Scholar] [CrossRef]
- Liu, W.; Li, H. COVID-19: Attacks the 1-beta chain of hemoglobin and captures the porphyrin to inhibit human heme metabolism. ChemRxiv 2020. [Google Scholar] [CrossRef]
- Moreira, A.C.; Mesquita, G.; Gomes, M.S. Ferritin: An Inflammatory Player Keeping Iron at the Core of Pathogen-Host Interactions. Microorganisma 2020, 8, 589. [Google Scholar] [CrossRef] [PubMed]
- Perricone, C.; Bartoloni, E.; Bursi, R.; Cafaro, G.; Guidelli, G.M.; Shoenfeld, Y.; Gerli, R. COVID-19 as part of the hyperferitinemic syndromes: The role of iron depletion therapy. Immunol. Res. 2020, 68, 213–224. [Google Scholar] [CrossRef]
- Cassat, J.E.; Skaar, E.P. Iron in Infection and Immunity. Cell Host Microbe 2013, 13, 509–519. [Google Scholar] [CrossRef]
- Rainey, N.E.; Moustapha, A.; Saric, A.; Nicolas, G.; Sureau, F.; Petit, P.X. Iron chelation by curcumin suppresses both curcumin-induced autophagy and cell death together with iron overload neoplastic transformation. Cell Death Discov. 2019, 5, 1–15. [Google Scholar] [CrossRef]
- Gardenghi, G. Pathophysiology of worsening lung function in COVID-19. Rev. Bras. Fisiol. Exerc. 2020, 19, 40–46. [Google Scholar] [CrossRef]
- Rawat, M.; Chandrasekharan, P.; Hicar, M.D.; Lakshminrusimha, S. COVID-19 in Newborns and Infants—Low Risk of Severe Disease: Silver Lining or Dark Cloud? Am. J. Perinatol. 2020, 37, 845–849. [Google Scholar] [CrossRef]
- Costagliola, G.; Spada, E.; Comberiati, P.; Peroni, D.G. Could nutritional supplements act as therapeutic adjuvants in COVID-19? Ital. J. Pediatr. 2021, 47, 1–5. [Google Scholar] [CrossRef]
- Wang, B.; Timilsena, Y.P.; Blanch, E.; Adhikari, B. Lactoferrin: Structure, function, denaturation and digestion. Crit. Rev. Food Sci. Nutr. 2017, 59, 580–596. [Google Scholar] [CrossRef]
- Wakabayashi, H.; Oda, H.; Yamauchi, K.; Abe, F. Lactoferrin for prevention of common viral infections. J. Infect. Chemother. 2014, 20, 666–671. [Google Scholar] [CrossRef]
- Campione, E.; Cosio, T.; Rosa, L.; Lanna, C.; Di Girolamo, S.; Gaziano, R.; Valenti, P.; Bianchi, L. Lactoferrin as Protective Natural Barrier of Respiratory and Intestinal Mucosa against Coronavirus Infection and Inflammation. Int. J. Mol. Sci. 2020, 21, 4903. [Google Scholar] [CrossRef] [PubMed]
- Lang, J.; Yang, N.; Deng, J.; Liu, K.; Yang, P.; Zhang, G.; Jiang, C. Inhibition of SARS Pseudovirus Cell Entry by Lactoferrin Binding to Heparan Sulfate Proteoglycans. PLoS ONE 2011, 6, e23710. [Google Scholar] [CrossRef] [PubMed]
- Peroni, D.G.; Fanos, V. Lactoferrin is an important factor when breastfeeding and COVID-19 are considered. Acta Paediatr. 2020, 109. [Google Scholar] [CrossRef] [PubMed]
- Peroni, D.G. Viral infections: Lactoferrin, a further arrow in the quiver of prevention. JPNIM 2020, 9, e090142. [Google Scholar]
- Kruzel, M.L.; Zimecki, M.; Actor, J.K. Lactoferrin in a Context of Inflammation-Induced Pathology. Front. Immunol. 2017, 8, 1438. [Google Scholar] [CrossRef]
- Bukowska-Ośko, I.; Popiel, M.; Kowalczyk, P. The Immunological Role of the Placenta in SARS-CoV-2 Infection—Viral Transmission, Immune Regulation, and Lactoferrin Activity. Int. J. Mol. Sci. 2021, 22, 5799. [Google Scholar] [CrossRef]

Publisher’s Note: MDPI stays neutral with regard to jurisdictional claims in published maps and institutional affiliations. |
© 2021 by the authors. Licensee MDPI, Basel, Switzerland. This article is an open access article distributed under the terms and conditions of the Creative Commons Attribution (CC BY) license (https://creativecommons.org/licenses/by/4.0/).
Share and Cite
Kucia, M.; Wietrak, E.; Szymczak, M.; Majchrzak, M.; Kowalczyk, P. Protective Action of L. salivarius SGL03 and Lactoferrin against COVID-19 Infections in Human Nasopharynx. Materials 2021, 14, 3086. https://doi.org/10.3390/ma14113086
Kucia M, Wietrak E, Szymczak M, Majchrzak M, Kowalczyk P. Protective Action of L. salivarius SGL03 and Lactoferrin against COVID-19 Infections in Human Nasopharynx. Materials. 2021; 14(11):3086. https://doi.org/10.3390/ma14113086
Chicago/Turabian StyleKucia, Marzena, Ewa Wietrak, Mateusz Szymczak, Michał Majchrzak, and Paweł Kowalczyk. 2021. "Protective Action of L. salivarius SGL03 and Lactoferrin against COVID-19 Infections in Human Nasopharynx" Materials 14, no. 11: 3086. https://doi.org/10.3390/ma14113086
APA StyleKucia, M., Wietrak, E., Szymczak, M., Majchrzak, M., & Kowalczyk, P. (2021). Protective Action of L. salivarius SGL03 and Lactoferrin against COVID-19 Infections in Human Nasopharynx. Materials, 14(11), 3086. https://doi.org/10.3390/ma14113086

